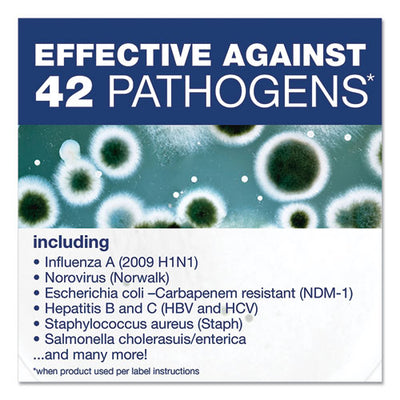
Disinfecting Cleaner With Bleach, Fresh Scent, 32 Oz Bottles, 8 Bottles And 2 Trigger Sprayers/carton

School Supplies
Filter and sort
Learn. Organize. Achieve.
Prepare for success with high-quality school supplies that cater to the needs of students, teachers, and schools alike. At Continental GS, we provide an extensive range of essentials, from durable pencil boxes to bulk classroom supplies, ensuring everyone is equipped to tackle every academic challenge with confidence.
School Supplies for All Ages
Back-to-School Must-Haves: Starting a new school year is easier with the right tools. Our back-to-school supplies include essentials like notebooks, pencils, and classroom essentials for teachers that help students stay focused and organized. Whether you’re setting up for a new school year or refreshing your supplies mid-year, we offer everything you need to create a successful learning environment.
Storage & Organization for Students: A clutter-free workspace enhances learning and productivity. Our storage & organization solutions, such as binders, folders, and bins, are designed to keep school materials neatly organized. From large classrooms to personal study spaces, these tools make managing school supplies simple and effective, promoting efficiency in any learning environment.
Bulk Supplies for Classrooms: Save time and money by shopping for bulk teacher supplies and classroom accessories. Whether you need markers, erasers, or storage bins, our bulk options ensure that every student has access to the tools they need to succeed. Ideal for schools and teachers preparing for the entire academic year, these products offer both convenience and affordability.
Shop Smarter with Continental GS
At Continental GS, we take the hassle out of shopping for school supplies by offering a comprehensive selection of high-quality products in one place. From basic essentials to innovative storage solutions, our supplies are designed to simplify classroom management and inspire both teachers and students.
Equip your classroom or study space with durable, practical, and reliable supplies that make every school day productive and organized. Explore our collection now and discover how Continental GS can support your educational journey.